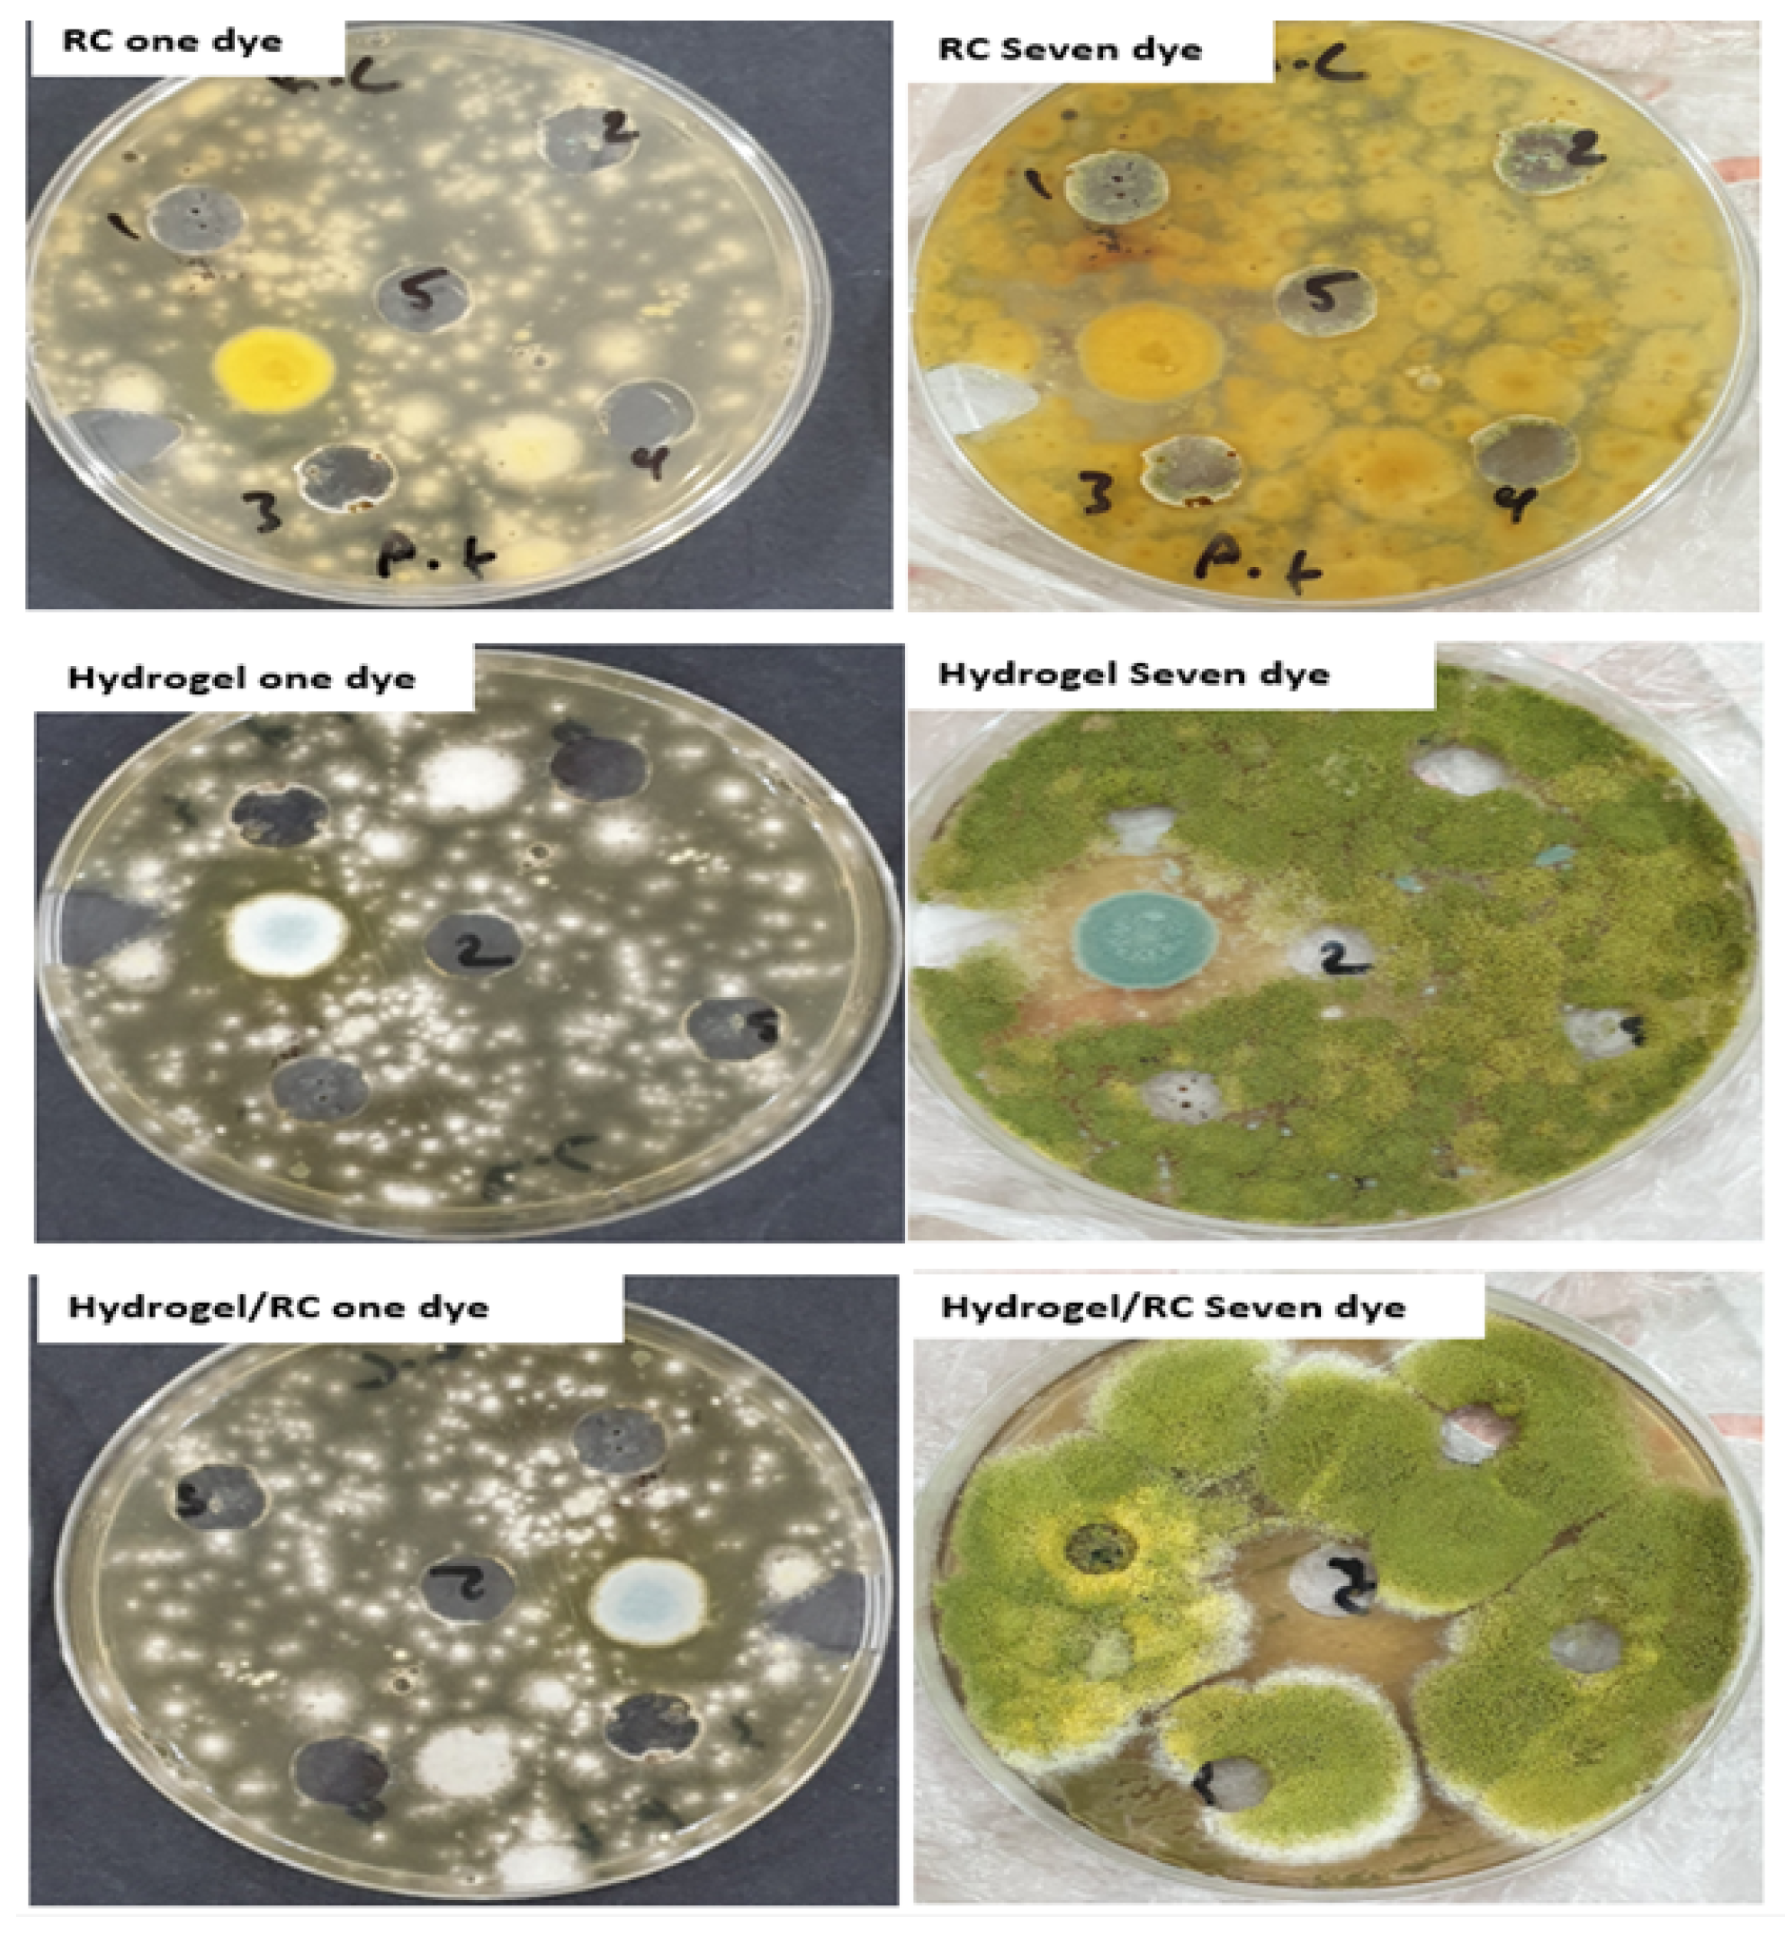
Engproc 59 00219 g004

Abstract
This study explores the biological activity, drug release properties, and wound healing efficacy of a novel hydrogel nanocomposite, (NaA-g-Poly(ITA-co-NaSS)/CPL). Firstly, the physicochemical properties of the hydrogel nanocomposite surface were characterized using FE-SEM and TEM imaging, demonstrating a solid, layered morphology with many interconnected pores. The nitrogen isothermal adsorption technique further supported these observations by indicating an enhanced surface area, pore diameter, and total pore volume following hydrogel incorporation. Secondly, the in vitro release of the drug chlorazepam from the hydrogel nanocomposite was investigated, revealing pH-responsive behavior with an increased release rate at a neutral to slightly alkaline pH (7.5). This is hypothesized to be due to the increased swelling of the hydrogel at this pH, facilitating drug dissolution and release. The study also examined the antimicrobial activity of the hydrogel nanocomposite against Gram-positive and Gram-negative bacteria, as well as a type of fungus, Aspergillus flavus. The hydrogel nanocomposite demonstrated superior antimicrobial activity in comparison to CPL and (NaA-g-Poly(ITA-co-NaSS). Lastly, the hydrogel nanocomposite exhibited enhanced wound healing efficiency in mice models, healing injuries faster and more effectively. In conclusion, this study suggests that the (NaA-g-Poly(ITA-co-NaSS)/ CPL) hydrogel nanocomposite holds significant promise for various biomedical applications due to its robust antimicrobial properties, pH-responsive drug release behavior, and wound healing capabilities.
1. Introduction
Hydrogels, three-dimensional polymeric networks, have an impressive ability to swell in water. In fact, the water content they can hold in suspension may be up to a thousand times the weight of the polymer itself. Their unique blend of elastic and glassy properties make them a subject of active research and wide-ranging applications. They are prevalent in various fields, including medicine, agriculture, food production, biotechnology, and pharmacy. A significant use of hydrogels is their role in controlling the release of pharmaceuticals [1,2,3,4]. The polymers, monomers, and cross-linking substances used in hydrogel production can greatly influence their physical and chemical properties. The resulting hydrogels comprise various chemical substances, leading to a multitude of potential applications. One of the major environmental concerns today is the removal of color from textile wastewater, which presents a significant challenge when using conventional treatment methods.
Waters with color are undesirable for consumption and agricultural purposes due to their aesthetic impacts. Multiple organizations have used diverse adsorbent materials to remove ionic and cationic dyes from aqueous solutions. The majority of these dyes are toxic, carcinogenic, and mutagenic, posing severe health risks. It is, therefore, crucial to remove color before discharging wastewater into natural water bodies. The use of cost-effective and biodegradable adsorbents within environmentally friendly processes could be an ideal approach to mitigate the environmental effects of manufacturing and textile waste [5,6,7,8,9,10]. Pseudomonas aeruginosa, a Gram-negative bacteria, is recognized as an opportunistic pathogen commonly associated with nosocomial infections and ventilator-associated pneumonia. While it rarely affects healthy individuals, it is a major cause of high morbidity and mortality among cystic fibrosis (CF) patients and immunocompromised individuals [11]. In contrast, Streptococcus pneumonia, a Gram-positive bacteria, exists as non-motile, non-spore-forming, alpha-hemolytic lancet-shaped diplococci or chains. It is resistant to bacitracin but sensitive to optochin and bile-mediated lysis. Given its incomplete biosynthetic pathways for numerous amino acids, Streptococcus pneumonia primarily relies on carbohydrate fermentation coupled to substrate-level phosphorylation for energy generation [12].
2. Method
2.1. Bacterial Biological Activity Test
Gram-positive (Streptococcus pneumonia) and Gram-negative (Pseudomonas aeruginosa) bacteria were sourced from the Department of Life Sciences at the College of Science for Women, University of Babylon. Both Hinton agar and mannitol salt agar were used as media for cultivation, isolation, and differentiation between the positive and negative bacteria. Aspergillus flavus, a type of fungus, was also obtained from the same department, with potato dextrose agar (PDA) serving as the medium for cultivation and activation of the fungus.
2.2. Preparation of Standard Solutions for Bacteria
A Mueller–Hinton agar medium was prepared by dissolving 37 g of the culture medium in 1 L of distilled water. This mixture was then heated until the agar fully dissolved. Following this, the culture medium was sterilized in an autoclave at 120 °C for 15 min. The medium was then poured into sterilized Petri dishes at a rate of 15–20 mL per plate. After waiting for complete solidification, the dishes were placed in an incubator at 37 °C for 24 h to ensure no contamination.
2.3. Preparation of Standard Solutions for Fungus
A Potato dextrose agar medium was prepared by dissolving 37 g of the culture medium in 1 L of distilled water. This solution was heated until the agar dissolved completely. The culture medium was then autoclaved at 120 °C for 15 min to sterilize it. Post sterilization, the medium was poured into sterilized Petri dishes at a rate of 15–20 mL per plate. After the medium solidified, the dishes were incubated at 37 °C for 24 h to ensure no contamination.
3. Results and Discussion
3.1. Physicochemical Characterization of Adsorbents Surfaces
The morphology of the (NaA-g-Poly(ITA-co-NaSS) hydrogel nanocomposite surface before and after loading with CPL was studied via FE-SEM and TEM, as shown in Figure 1. The images depict many active sites before loading, which were mostly filled with CPL post-loading, resulting in a more solid surface [13,14]. The TEM image clearly shows the layered morphology of the nanocomposite and less uniformity due to the presence of interconnected channels of pores [15].
Figure 1.
FESEM (a) (NaA-g-Poly(ITA-co-NaSS) hydrogel, (b) (NaA-g-Poly(ITA-co-NaSS)/CPL) hydrogel nanocomposite and TEM, (c) (NaA-g-Poly(ITA-co-NaSS), (d) (NaA-g-Poly(ITA-co-NaSS)/CPL).
The nitrogen isothermal adsorption technique was employed to determine the surface area and pore structure of the (NaA-g-Poly(ITA-co-NaSS)/ CPL) hydrogel nanocomposite. The surface area, average pore diameter, and total pore volume were found to be enhanced after hydrogel incorporation onto the grafted CPL (Table 1). This study demonstrates that interfacial interactions between the hydrogel and CPL greatly influence the pore structure of the material [16].
Table 1.
Surface physical characteristics of hydrogel nanocomposite.
3.2. Effect of pH on the Release Ratio of Chlorazepam Drug In Vitro
The release of the CLZ drug was studied under conditions mimicking the human body’s acidity and temperature. It was observed that the release speed of chlorazepam was higher at a pH of 7.5 due to the hydrogel’s degree of swelling and chlorazepam dissolution depending on pH. At a pH of 1.2, the hydrogel swelling percentage and the drug release rate decreased due to the increased concentration of H+. The initial burst was observed at 68% and 18% in the first hour for chlorazepam, with a cumulative release of 81% and 20% in 3 h at pH = 7.5 and pH = 1.2, respectively (Figure 2).
Figure 2.
Release control of chlorazepam drug.
3.3. Biological Activity of Bacterial Test
The antibacterial activity of Aspergillus flavus, Gram-positive bacteria (staphylococcus), and Gram-negative bacteria (Pseudomonas) was tested using CPL, (NaA-g-Poly(ITA-co-NaSS), and (NaA-g-Poly(ITA-co-NaSS)/CPL) hydrogel nanocomposite surfaces. These surfaces demonstrated varying levels of antibacterial activity at different concentrations against both types of bacteria. It was observed that the CPL-loaded hydrogel demonstrated increased antibacterial efficiency [17,18] (Figure 3). Furthermore, the antifungal activity against Aspergillus flavus was studied. An increase in fungal inhibition was observed with increased time and concentration. The (NaA-g-Poly(ITA-co-NaSS)/CPL) hydrogel nanocomposite was the most efficient in inhibiting fungi, followed by (NaA-g-Poly(ITA-co-NaSS) and CPL [19,20] (Figure 4).
Figure 3.
Anti-bacterial activities of the (A) Gram-positive bacteria and (B) Gram- negative bacteria using disc diffusion method.
Figure 4.
Biological activity of fungus (Aspergillus flavus) on three surfaces of (NaA-g-Poly(ITA-co-NaSS)/ CPL) hydrogel nanocomposite.
3.4. Efficacy of Surface Treatment in Mice Wound Healing
An amount of 0.1 g of the prepared surface from (CPL) and (NaA-g-Poly(ITA-co-NaSS) was applied to wounds, as depicted in Figure 5A. On the second day, a slight improvement was noticeable in wound recovery, marking the initial stages of healing (Figure 5B). Between the third and seventh days, the wounds showed a significant improvement with some evident skin redness surrounding the injury, as portrayed in Figure 5C–E. By the fourteenth day, the wounds had fully healed, with the skin reverting to its natural tone albeit a minor remaining burn effect (Figure 5F) [21]. The rapid healing is attributable to the high efficiency of CPL leaves and the hydrogel in wound treatment. These materials are eco-friendly, non-toxic, and possess anti-inflammatory properties (Figure 5 and Figure 6).
Figure 5.
Effect of the surface CPL on the wound healing of mice during fourteen days (A–F).
Figure 6.
Effect of the surface hydrogel on the wound healing of mice during fourteen days (a–f).
When employing the hydrogel loaded with CPL, the wound healing efficiency in mice noticeably increased during the early wound stages, as seen in Figure 6. On the first day, the mice exhibited clear wounds, which were then treated with 0.1 g of the (NaA-g-Poly(ITA-co-NaSS)/CPL) hydrogel nanocomposite surface (Figure 7a). From the second to the third day, the mice showed noticeable improvements, with evident skin redness surrounding the injury site (Figure 7b,c). By the fourth and fifth day, the wounds had significantly healed, and the skin returned to its natural pink hue, indicating the efficacy of the surface treatment in wound healing (Figure 7d–e) [22]. On the seventh day, the mice showed complete recovery with the skin returning to its normal color and the burn scar noticeably fading (Figure 7f). This result confirms the high efficiency of the hydrogel nanocomposite in treating and healing wounds. The hydrogel is not only environmentally friendly and non-toxic but also demonstrates anti-inflammatory properties and biocompatibility with mammalian cells [23,24,25]. The results presented in this study provide substantial evidence for the high antibacterial, antifungal, and wound healing properties of the hydrogel nanocomposite surface. Both the FE-SEM and TEM images indicated a considerable transformation in the surface morphology after CPL loading, suggesting an increase in active site accessibility for biological activity [13,14,15].
Figure 7.
Effect of the surface hydrogel on the wound healing of mice during seven days (a–f).
The nitrogen isothermal adsorption technique used to characterize the pore structure revealed that the CPL–hydrogel interaction significantly improved the surface area, average pore diameter, and total pore volume [16]. Further, the drug release ratio of chlorazepam was considerably affected by pH. The observed accelerated release in an alkaline medium (pH = 7.5) is associated with enhanced hydrogel swelling compared to an acidic medium (pH = 1.2). The abundance of H+ ions in the acidic medium possibly competes with the unbound amino groups, limiting the hydrogel’s swelling capacity and subsequently the drug release rate [22]. This pattern of pH-dependent release suggests potential applications of this hydrogel nanocomposite in controlled drug delivery systems.
The antimicrobial activity studies revealed the superior performance of the CPL-loaded hydrogel nanocomposite against both bacterial strains and the fungus Aspergillus flavus. The incorporation of CPL into the hydrogel significantly increased the antibacterial efficiency, particularly against Gram-negative bacteria (Pseudomonas) [17,18]. Furthermore, the hydrogel nanocomposite also demonstrated higher antifungal activity, indicating its broad-spectrum antimicrobial properties [19,20]. In wound healing assays, the CPL-loaded hydrogel nanocomposite expedited the healing process in mice, with wounds completely healing by the seventh day. The presence of CPL could contribute to the enhancement of the healing process due to its non-toxic, anti-inflammatory, and eco-friendly properties [21,23,24,25]. The quick healing rate, combined with the antimicrobial efficiency of the hydrogel nanocomposite, suggests its promise as a bioactive wound dressing material.
3.5. Future Scope and Generalizability
While this study offers substantial evidence of the superior antimicrobial and wound healing properties of the CPL-loaded hydrogel nanocomposite, further research is recommended. It would be beneficial to investigate the exact mechanism of action underlying the antimicrobial activity and the wound healing process. This could involve genomic and proteomic studies to ascertain the changes induced in the microbes and the wound tissues due to the presence of the hydrogel nanocomposite. The scalability of the hydrogel nanocomposite production process could also be assessed for potential commercial applications. Moreover, the safety and efficacy of this material could be examined in different animal models and ultimately human clinical trials to understand its applicability in real-world medical and pharmaceutical settings. The findings from this study could be extrapolated to design and develop similar hydrogel-based nanocomposites employing different bioactive agents. This opens up a vast area for future exploration and application, potentially revolutionizing wound care, drug delivery, and antimicrobial coatings.
4. Conclusions
This study extensively examined the biological activity of the hydrogel nanocomposite (NaA-g-Poly(ITA-co-NaSS)/CPL) against a type of fungus, Aspergillus flavus, and two types of bacteria, Gram-positive bacteria (Staphylococcus) and Gram-negative bacteria (Pseudomonas). Comparative analysis was performed against the antibacterial activity of two other surfaces, CPL and (NaA-g-Poly(ITA-co-NaSS). The results suggest that the hydrogel nanocomposite demonstrates a superior antibacterial and antifungal activity. Particularly, the (NaA-g-Poly(ITA-co-NaSS)/CPL) hydrogel nanocomposite exhibited potent activity, indicating its potential as an effective antimicrobial agent. Furthermore, the study revealed the pH-responsive release behavior of the drug chlorazepam from the hydrogel nanocomposite. It was observed that the release rate was significantly higher at a neutral to slightly alkaline pH (pH = 7.5). This phenomenon can be attributed to the increased swelling of the hydrogel at this pH, which facilitates the dissolution and subsequent release of chlorazepam.
Author Contributions
Conceptualization, A.M.A. and I.T.H.; methodology, A.M.A.; software, M.M.J.; validation, A.M.A., A.H.D. and M.A.J.; formal analysis, M.M.J.; investigation, A.H.D.; resources, M.A.J.; data curation, M.M.J.; writing—original draft preparation, A.M.A.; writing—review and editing, I.T.H.; visualization, M.M.J.; supervision, I.T.H.; project administration, A.H.D. and M.A.J. All authors have read and agreed to the published version of the manuscript.
Funding
This research received no external funding.
Institutional Review Board Statement
Ethical review and approval were waived for this study due to normal checking for the effect of the prepared surface and its role in healing.
Informed Consent Statement
Not applicable.
Data Availability Statement
All the data used in the experiment have been made available in the present article.
Conflicts of Interest
The authors declare no conflicts of interest.
References
- Pashaei-Fakhri, S.; Peighambardoust, S.J.; Foroutan, R.; Arsalani, N.; Ramav, I.B. Crystal violet dye sorption over acrylamide/graphene oxide bonded sodium alginate nanocomposite hydrogel. Chemosphere 2021, 270, 129419. [Google Scholar] [CrossRef] [PubMed]
- Radia, N.D.; Mahdi, A.B.; Mohammed, G.A.; Sajid, A.; Altimari, U.S.; Shams, M.A.; Aljeboree, A.M.; Fh, A. Removal of Rose Bengal Dye from Aqueous Solution using Low Cost (SA-g-PAAc) Hydrogel: Equilibrium and Kinetic Study. Int. J. Drug Deliv. Technol. 2022, 12, 957–960. [Google Scholar] [CrossRef]
- Radia, N.D.; Kamona, S.M.H.; Jasem, H.; Abass, R.R.; Izzat, S.E.; Ali, M.S.; Ghafel, S.T.; Am, A. Role of Hydrogel and Study of its High-Efficiency to Removal Streptomycin drug from Aqueous Solutions. Int. J. Pharm. Qual. Assur. 2022, 13, 160–163. [Google Scholar]
- Naderi, P.; Kabiri, K.; Jahanmardi, R.; Zohuriaan-Mehr, M.J. Preparation of itaconic acid bio-based cross-linkers for hydrogels. J. Macromol. Sci. Part A 2022, 12, 12–18. [Google Scholar] [CrossRef]
- Thakur, S.; Chaudhary, J.; Thakur, A.; Gunduz, O.; Alsanie, W.F.; Makatsoris, C.; Thakur, V.K. Highly efficient poly(acrylic acid-co-aniline) grafted itaconic acid hydrogel: Application in water retention and adsorption of rhodamine B dye for a sustainable environment. Chemosphere 2022, 303, 134917. [Google Scholar] [CrossRef]
- Wared, S.H.H.; Radia, N.D. Synthesis and characterization of sodium alginate-g-polyacrylic acid hydrogel and its application for crystal violet dye adsorption. Int. J. Drug Deliv. Technol. 2021, 11, 556–565. [Google Scholar]
- Thakur, S. Synthesis, characterization and adsorption studies of an acrylic acid-grafted sodium alginate-based TiO2 hydrogel nanocomposite. Adsorpt. Sci. Technol. 2018, 36, 458–477. [Google Scholar] [CrossRef]
- Alkaim, A.F.; Ajobree, A.M. White marble as an alternative surface for removal of toxic dyes (Methylene blue) from Aqueous solutions. Int. J. Adv. Sci. Technol. 2020, 29, 5470–5479. [Google Scholar]
- Karam, F.F.; Kadhim, M.I.; Alkaim, A.F. Optimal conditions for synthesis of 1, 4-naphthaquinone by photocatalytic oxidation of naphthalene in closed system reactor. Int. J. Chem. Sci. 2015, 13, 650–660. [Google Scholar]
- Al-Gubury, H.Y.; Fairooz, N.Y.; Aljeboree, A.M.; Alqaraguly, M.B.; Alkaim, A.F. Photocatalytic degradation n-undecane using coupled ZnO-Co2O3. Int. J. Chem. Sci. 2015, 13, 863–874. [Google Scholar]
- Abd, F.G.; Mohsen, L.Y.; Al Shalah, L.A.M.; Alkaim, A.F. Silver nanoparticles synthesized by using Pseudomonas aeruginosa synergistically act with antibiotic. Asian J. Microbiol. Biotechnol. Environ. Sci. 2018, 20, S50–S52. [Google Scholar]
- Alabdali, Y.A.J.; Wali, H.F.; Alkaim, A.F. ZnO nanoparticles activity against the virulence gene of Pseudomonas aeruginosa isolated from patients with burn wounds infection in Al Muthanna population. Ann. Trop. Med. Public Health 2020, 23, 1032–1041. [Google Scholar] [CrossRef]
- Aljeboree, A.M.; Alkaim, A.F. Comparative removal of three textile dyes from aqueous solutions by adsorption: As a model (corn-cob source waste) of plants role in environmental enhancement. Plant Arch. 2019, 19, 1613–1620. [Google Scholar]
- Aljeboree, A.M.; Hussein, F.H.; Alkaim, A.F. Removal of textile dye (methylene blue mb) from aqueous solution by activated carbon as a model (corn-cob source waste of plant): As a model of environmental enhancement. Plant Arch. 2019, 19, 906–909. [Google Scholar]
- Bader, A.T.; Aljeboree, A.M.; Alkaim, A.F. Removal of Methyl Violet (MV) from aqueous solutions by adsorption using activated carbon from pine husks (plant waste sources). Plant Arch. 2019, 19, 898–901. [Google Scholar]
- Jawad, M.A.; Kadhim, A.J.; Radia, N.D. Role of sodium alginate-g-poly (Acrylic acid-fumaric acid) hydrogel for removal of pharmaceutical paracetamol from aqueous solutions by adsorption. Int. J. Pharm. Qual. Assur. 2021, 12, 202–205. [Google Scholar]
- Hammadi, A.H.; Habeeb, S.A.; Al-Jibouri, L.F.; Hussien, F.H. Synthesis, Characterization and Biological Activity of Zinc Oxide Nanoparticles (ZnO NPs). Syst. Rev. Pharm. 2020, 11, 431–439. [Google Scholar]
- Adam, A.M.A. Structural, thermal, morphological and biological studies of proton-transfer complexes formed from 4-aminoantipyrine with quinol and picric acid. Spectrochim. Acta Part A Mol. Biomol. Spectrosc. 2010, 104, 1–13. [Google Scholar] [CrossRef]
- Mundra, R.V.; Wu, X.; Sauer, J.; Dordick, J.S.; Kane, R.S. Nanotubes in biological applications. Curr. Opin. Biotechnol. 2014, 28, 25–32. [Google Scholar] [CrossRef]
- Mukha, I.P.; Eremenko, A.M.; Smirnova, N.P.; Mikhienkova, A.I.; Korchak, G.I.; Gorchev, V.F.; Chunikhin, A.Y. Antimicrobial activity of stable silver nanoparticles of a certain size. Appl. Biochem. Microbiol. 2019, 49, 199–206. [Google Scholar] [CrossRef]
- He, J.; Shi, M.; Liang, Y.; Guo, B. Conductive adhesive self-healing nanocomposite hydrogel wound dressing for photothermal therapy of infected full-thickness skin wounds. Chem. Eng. J. 2020, 394, 124888. [Google Scholar] [CrossRef]
- Liu, Y.; Song, S.; Liu, S.; Zhu, X.; Wang, P. Application of Nanomaterial in Hydrogels Related to Wound Healing. Adv. Nanocomposite Hydrogels Tissue Eng. 2022, 12, 4656037. [Google Scholar] [CrossRef]
- Xu, D.; Wang, S.; Li, B.; Qi, M.; Feng, R.; Li, Q.; Zhang, H.; Chen, H.; Kong, M.G. Effects of Plasma-Activated Water on Skin Wound Healing in Mice. Microorganisms 2020, 7, 1091. [Google Scholar] [CrossRef]
- Vågesjö, E.; Öhnstedt, E.; Mortier, A.; Lofton, H.; Huss, F.; Proost, P.; Roos, S.; Phillipson, M. Accelerated wound healing in mice by on-site production and delivery of CXCL12 by transformed lactic acid bacteria. Natl. Cent. Biotechnol. Inf. 2018, 7, 1–9. [Google Scholar] [CrossRef]
- Afrin, S.; Shahruzzaman, M.; Haque, P.; Islam, M.S.; Hossain, S.; Rashid, T.U.; Ahmed, T.; Takafuji, M.; Rahman, M.M. Advanced CNC/PEG/PDMAA Semi-IPN Hydrogel for Drug Delivery Management in Wound Healing. Gels 2022, 8, 340. [Google Scholar] [CrossRef] [PubMed]
Disclaimer/Publisher’s Note: The statements, opinions and data contained in all publications are solely those of the individual author(s) and contributor(s) and not of MDPI and/or the editor(s). MDPI and/or the editor(s) disclaim responsibility for any injury to people or property resulting from any ideas, methods, instructions or products referred to in the content. |
© 2024 by the authors. Licensee MDPI, Basel, Switzerland. This article is an open access article distributed under the terms and conditions of the Creative Commons Attribution (CC BY) license (https://creativecommons.org/licenses/by/4.0/).